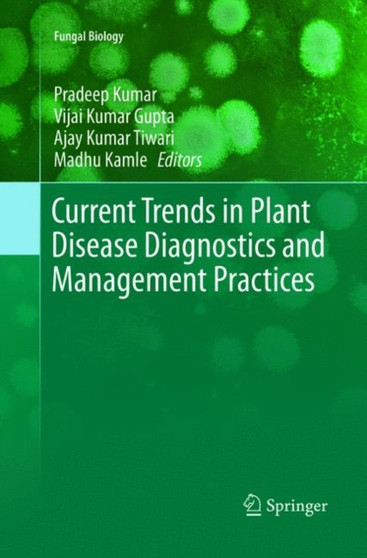
Current Trends in Plant Disease Diagnostics and Management Practices by Pradeep Kumar - Paperback

Product Description
ISBN: 9783319801131
TITLE: Current Trends in Plant Disease Diagnostics and Management Practices
AUTHOR: Pradeep Kumar
PUBLISHER: Springer International Publishing AG
PUBLISHER DATE: 31 May 2018
 AED
AED AED
AED
ISBN: 9783319801131
TITLE: Current Trends in Plant Disease Diagnostics and Management Practices
AUTHOR: Pradeep Kumar
PUBLISHER: Springer International Publishing AG
PUBLISHER DATE: 31 May 2018
Popular Trending Products

ISBN: 9783319273105TITLE: Current Trends in Plant Disease Diagnostics and Management PracticesAUTHOR…

ISBN: 9780323851930TITLE: Microbial Management of Plant Stresses : Current Trends, Application and C…

ISBN: 9781774631577TITLE: Advances in Microbial Biotechnology : Current Trends and Future ProspectsA…

ISBN: 9781774634639TITLE: Plant Pathogens : Detection and Management for Sustainable AgricultureAUTH…

ISBN: 9781789851151TITLE: Plant Diseases : Current Threats and Management TrendsAUTHOR: Snjezana Top…

